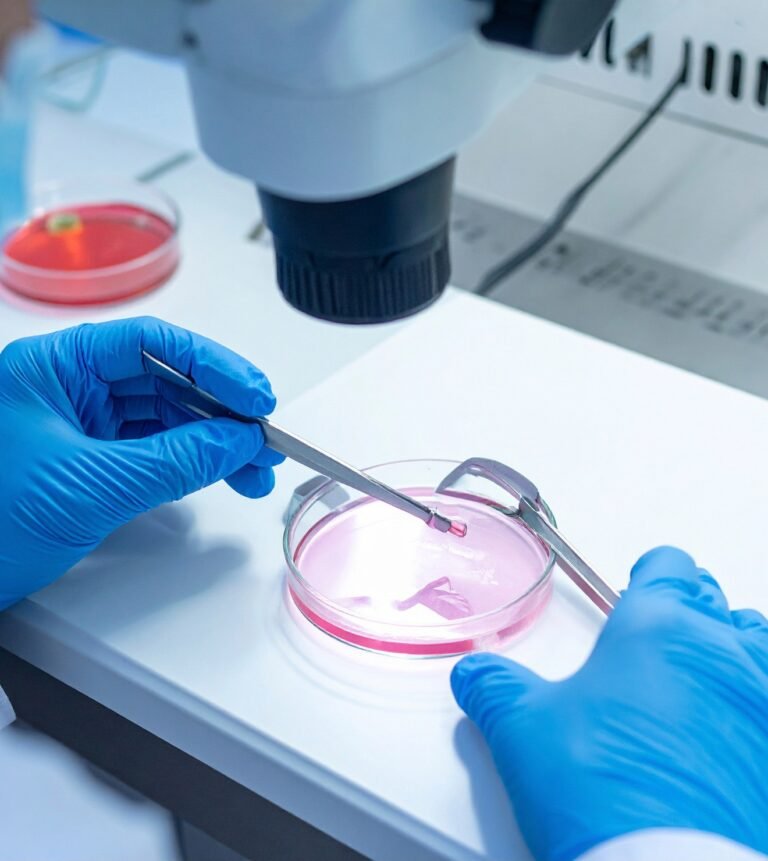
tanda sperma subur

Meningkatkan peluang hamil alami memerlukan pengetahuan yang mendalam tentang siklus reproduksi serta tingkat kualitas sperma pria secara keseluruhan. Meskipun ada kondisi yang tidak normal, tubuh masih dapat memproduksi sel yang sehat dengan cara perawatan yang tepat.
Pria dengan jumlah sperma yang rendah masih punya kesempatan untuk mencapai kehamilan dengan memperbaiki gaya hidup mereka. Mengonsumsi nutrisi tertentu dapat membantu proses penyembuhan sel yang terganggu karena dampak polusi dan radikal bebas.
Genetik memang memengaruhi, tetapi pola makan sehari-hari jauh lebih berpengaruh dalam menjaga kesuburan. Mengonsumsi sayuran hijau secara rutin dapat memberikan asupan asam folat yang sangat penting bagi sistem reproduksi.
Pria yang secara teratur memperhatikan asupan makanan bergizi akan mengalami peningkatan positif pada kesehatan tubuh mereka. Perubahan kecil ini dapat memberikan efek besar terhadap kesehatan jangka panjang dan kualitas hidup keluarga di masa depan.
Baca: Mengapa Sering Berendam Air Panas Bisa Merusak Sperma?
Faktor Penentu Peluang Hamil Alami Pria
Keberhasilan dalam meningkatkan peluang hamil alami sangat bergantung pada tingkat motilitas atau kemampuan berenang sel benih tersebut. Sel yang lincah akan lebih mudah menembus dinding sel telur meskipun jumlah sel secara keseluruhan sedikit.
Gaya hidup sehat seperti menjauhi kebiasaan merokok dapat meningkatkan kualitas materi genetik dalam sel reproduksi pria. Racun dalam rokok seringkali menjadi penyebab utama terjadinya kerusakan pada struktur kepala sel benih tersebut.
Pria harus memastikan bahwa waktu tidur malam mereka mencukupi agar proses regenerasi sel berjalan sangat lancar. Hormon yang mengatur kesuburan diproduksi paling maksimal saat tubuh sedang berada dalam kondisi istirahat total.
Menghindari paparan polusi udara berlebih membantu paru-paru menyalurkan oksigen bersih ke seluruh jaringan tubuh pria. Oksigen yang cukup sangat penting untuk menjaga kebugaran sel agar tetap aktif bekerja secara optimal.
Baca: Gaya Hidup Modern: Pemicu Utama Infertilitas
Pentingnya Antioksidan untuk Kesuburan
Antioksidan alami dari buah-buahan seperti delima terbukti mampu melindungi sel dari serangan stres oksidatif yang berbahaya. Zat ini bekerja dengan cara menetralkan racun sehingga peluang hamil alami menjadi semakin besar bagi pasangan.
Vitamin C dan E juga berperan penting dalam mencegah terjadinya penggumpalan sel benih saat proses pembuahan. Sel yang terpisah secara individu memiliki kesempatan lebih besar untuk mencapai tujuan akhir dengan sangat cepat.
Mengonsumsi biji-bijian yang kaya akan kandungan zinc membantu meningkatkan kadar testosteron secara alami di dalam tubuh. Testosteron yang stabil merupakan kunci utama pria dalam memproduksi sel reproduksi yang berkualitas serta fungsional.
Keseimbangan antara karbohidrat kompleks dan protein sangat menunjang ketersediaan energi cadangan bagi fisik pria dewasa. Nutrisi yang seimbang mencegah kelelahan dini yang seringkali menurunkan gairah dalam menjalani rutinitas harian.
Baca: Penyebab Sperma Lambat yang Jarang Disadari
Aktivitas Fisik dan Aliran Darah
Melakukan olahraga ringan secara teratur mampu melancarkan aliran darah menuju seluruh jaringan organ reproduksi pria dewasa. Aliran darah yang lancar memastikan nutrisi terserap sempurna oleh kelenjar yang bertanggung jawab memproduksi sel benih.
Pria yang menjaga berat badan ideal cenderung memiliki keseimbangan hormon yang jauh lebih baik daripada pria obesitas. Lemak tubuh yang berlebih dapat mengubah hormon testosteron menjadi estrogen yang justru menurunkan tingkat kesuburan.
Menghindari pakaian dalam yang terlalu ketat juga membantu menjaga suhu testis tetap stabil untuk memproduksi sel. Suhu yang terlalu panas akan mematikan sel benih sebelum mereka sempat menjalankan fungsinya untuk membuahi.
Baca: Nikotin Merusak DNA Sperma Fakta atau Mitos
Strategi Meningkatkan Peluang Hamil Alami
Menerapkan strategi yang tepat dalam hubungan suami istri akan membantu memperbesar peluang hamil alami bagi setiap pasangan. Mengetahui masa subur pasangan wanita merupakan langkah cerdas agar pertemuan sel reproduksi terjadi pada waktu tepat.
Pria perlu menjaga kondisi psikologis agar tetap tenang dan terhindar dari stres berat selama menjalani program. Stres yang berkepanjangan dapat mengganggu kualitas semen sehingga menghambat pergerakan sel benih menuju ke sel telur.
Memperbanyak konsumsi air putih membantu menjaga viskositas atau kekentalan cairan semen tetap berada pada batas normal. Cairan yang tidak terlalu kental akan memudahkan sel benih berenang bebas menuju sasarannya dengan kekuatan penuh.
Kebiasaan minum air mineral yang cukup juga mendukung fungsi ginjal dalam menyaring sisa-sisa metabolisme tubuh. Tubuh yang bersih dari tumpukan limbah kimia akan merespons nutrisi pendukung kesuburan dengan lebih cepat.
Baca: Penyebab Utama Sperma Abnormal
Vertomen Sebagai Solusi Pendukung Kesuburan
Dukungan dari Vertomen yang mengandung ekstrak jahe merah dan pasak bumi sangat membantu dalam meningkatkan produksi sperma. Kandungan alaminya bekerja secara efektif memperbaiki kualitas sel benih agar pria menjadi jauh lebih sehat dan subur.

Vertomen juga bermanfaat mengentalkan sperma yang secara langsung berpengaruh besar pada keberhasilan program kehamilan bagi pasangan baru. Produk herbal ini merupakan pilihan tepat bagi pria yang ingin mendukung kesehatan reproduksi dengan cara aman.
Pencapaian peluang hamil alami akan terasa lebih nyata jika pria rutin mengonsumsi kapsul herbal berkualitas tinggi ini. Segera mulai langkah sehat Anda untuk masa depan keluarga yang bahagia dengan kualitas reproduksi yang lebih optimal.
Dapatkan produk Vertomen sekarang juga melalui tombol di bawah untuk meningkatkan kualitas serta kesuburan pria sejati.